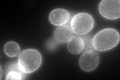
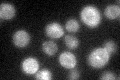

View description
High affinity iron permease involved in the transport of iron across the plasma membrane; forms complex with Fet3p; expression is regulated by iron
Localization:
Intensity:
Fold change:
Significance:
-
C’ GFP library in SD
cell periphery137.8 -
N' NOP1pr-GFP in SD

ER24.806 -
N' TEF2pr-mCherry in SD

below threshold5.0972 -
N' NATIVEpr-GFP in SD

below threshold18.5933 -
N' TEF2pr-VC and Cyto-VN in SD

#N/A0 -
C’ GFP library in SD+DTT

cell periphery71.250.51Yes -
C’ GFP library in SD+H2O2

cell periphery141.711.02No -
C’ GFP library in Starvation Media
cell periphery66.470.48Yes -
C’ GFP library on the background of Pup2-DaMP

cell periphery -
C’ GFP library on the background of CCT mutant

cell periphery135.8340.985709No
